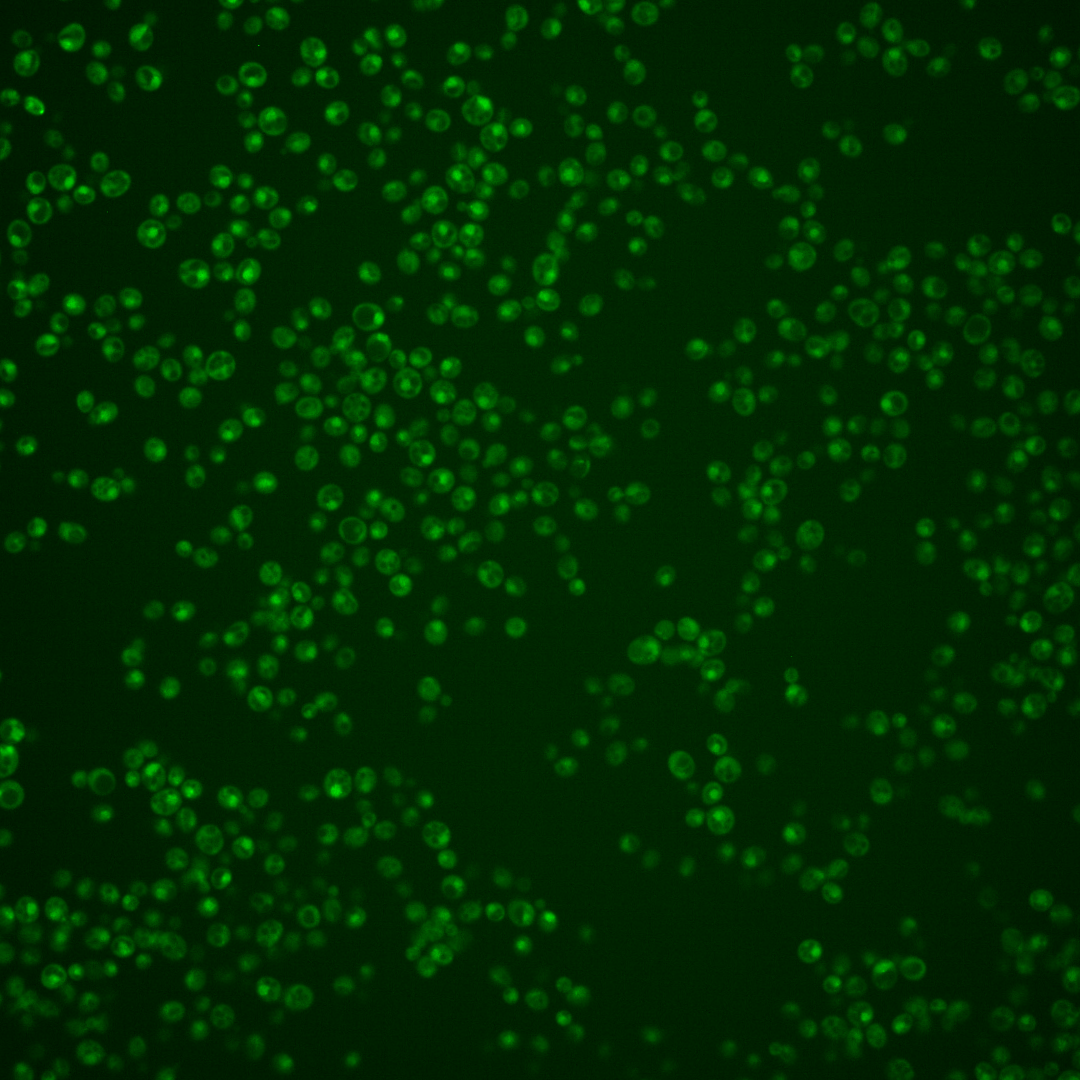
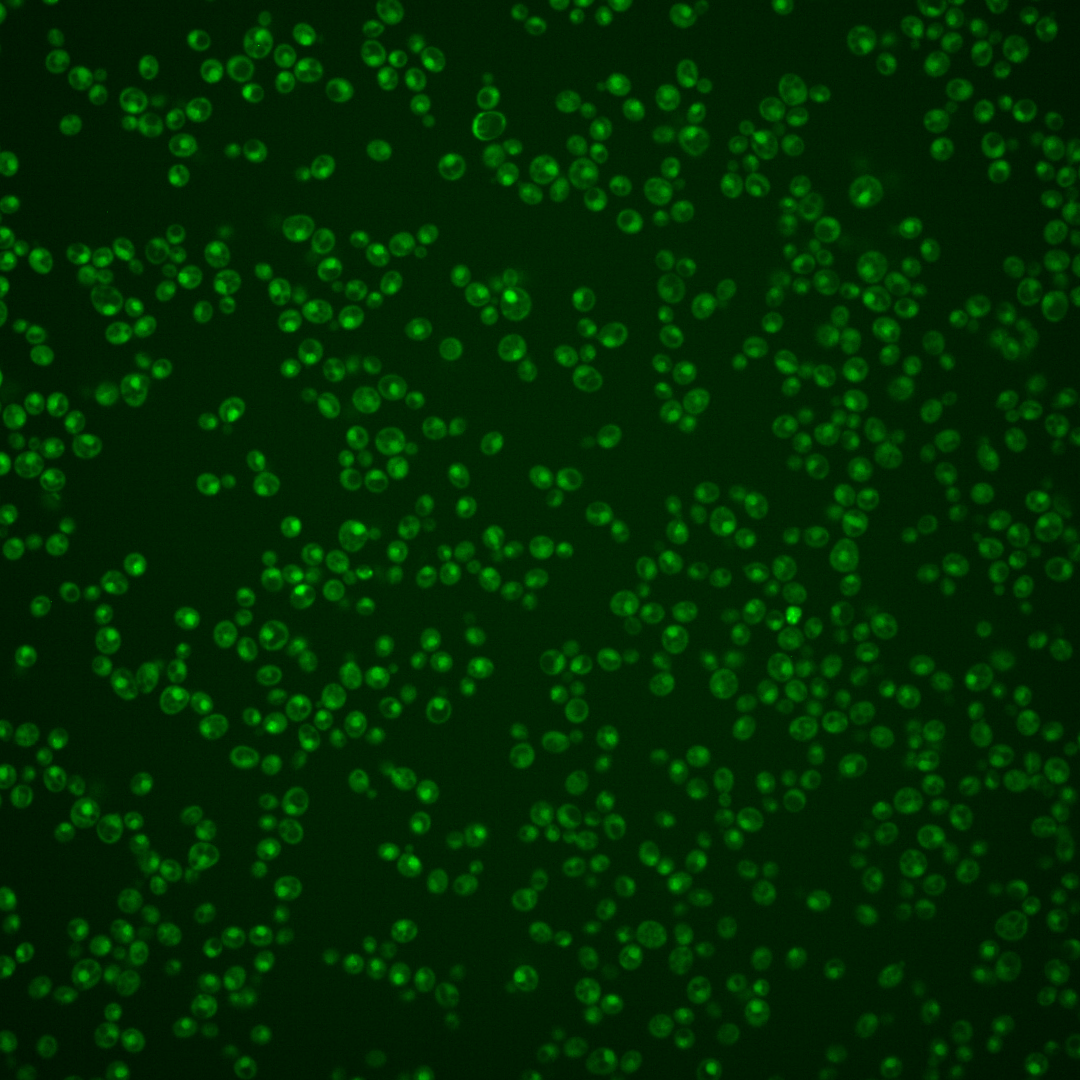
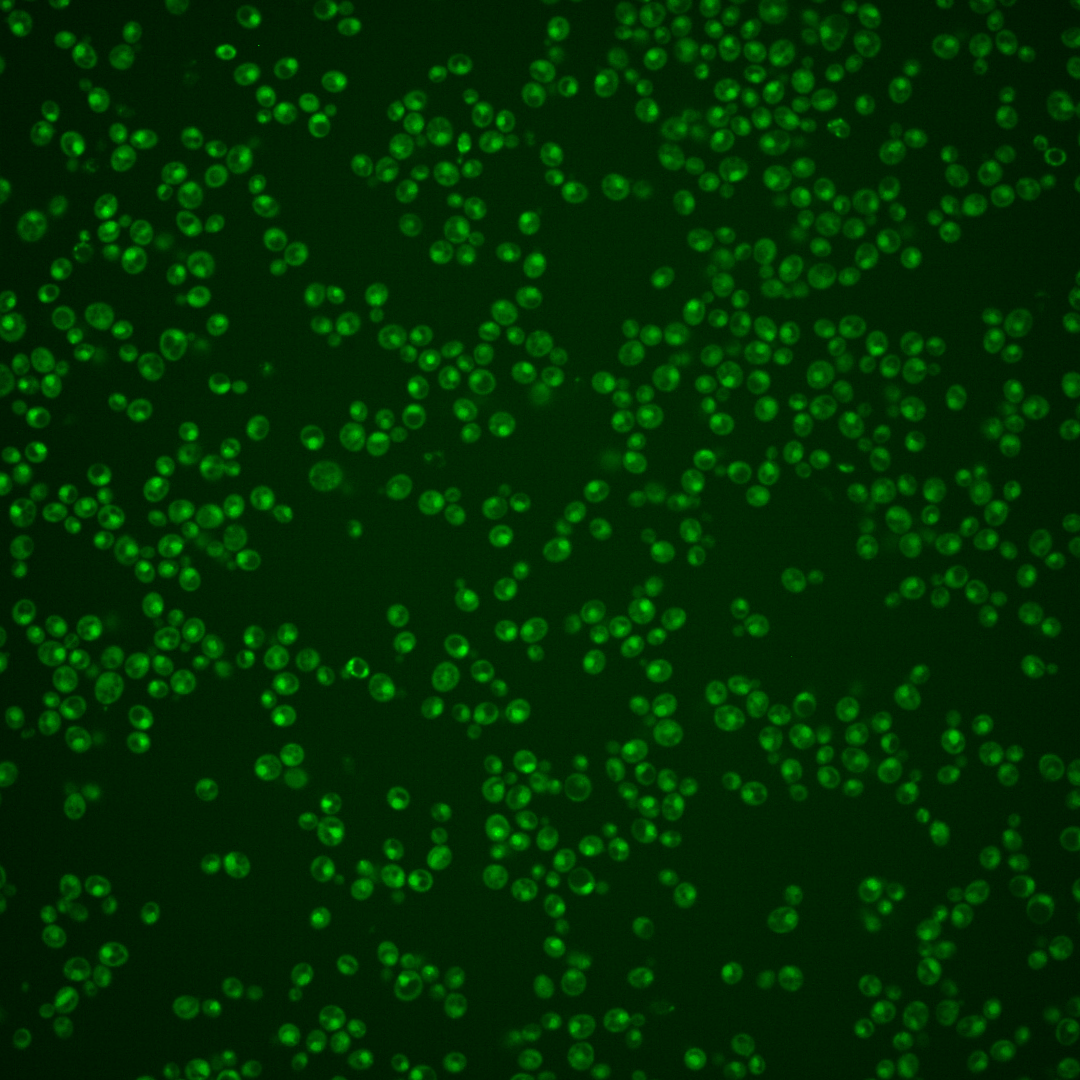

| Standard name | |
|---|---|
| Human Ortholog | |
| Description | Subunit of the telomeric Ku complex (Yku70p-Yku80p); involved in telomere length maintenance, structure and telomere position effect; required for localization of telomerase ribonucleoprotein to nucleus via interaction with the TLC1 guide RNA; relocates to sites of double-strand cleavage to promote nonhomologous end joining during DSB repair |
Micrographs




















































































Sub-cellular Localization
Yeast GFP Assignment
Protein Abundance
Localization Change
External localization resources
| ensLOC | DeepLoc | |||||||||||||||||||||||
|---|---|---|---|---|---|---|---|---|---|---|---|---|---|---|---|---|---|---|---|---|---|---|---|---|
| Localization | WT1 | WT2 | WT3 | RAP60 | RAP140 | RAP220 | RAP300 | RAP380 | RAP460 | RAP540 | RAP620 | RAP700 | HU80 | HU120 | HU160 | rpd3Δ_1 | rpd3Δ_2 | rpd3Δ_3 | WT1 | WT2 | WT3 | AF100 | AF140 | AF180 |
| Cortical Patches | 0 | 0 | – | 0 | 0 | 0 | 0 | – | 0 | 0 | 0 | 0 | – | – | – | 0 | 0 | 0 | 0 | 1 | 0 | 0 | 0 | 0 |
| Bud | 0 | 0 | – | 0 | 0 | 1 | 0 | – | 1 | 1 | 3 | 2 | – | – | – | 0 | 2 | 0 | 2 | 5 | 1 | 0 | 0 | 0 |
| Bud Neck | 0 | 0 | – | 0 | 2 | 1 | 1 | – | 0 | 1 | 1 | 0 | – | – | – | 0 | 0 | 0 | 1 | 0 | 0 | 0 | 0 | 0 |
| Bud Site | 1 | 0 | – | 0 | 0 | 0 | 0 | – | 0 | 1 | 2 | 3 | – | – | – | 0 | 0 | 1 | – | – | – | – | – | – |
| Cell Periphery | 0 | 1 | – | 0 | 0 | 0 | 0 | – | 0 | 0 | 0 | 0 | – | – | – | 1 | 0 | 0 | 0 | 0 | 0 | 0 | 0 | 0 |
| Cytoplasm | 17 | 12 | – | 1 | 11 | 12 | 13 | – | 3 | 9 | 14 | 7 | – | – | – | 26 | 22 | 14 | 11 | 4 | 2 | 0 | 1 | 1 |
| Endoplasmic Reticulum | 0 | 1 | – | 0 | 0 | 0 | 0 | – | 0 | 0 | 0 | 1 | – | – | – | 8 | 10 | 8 | 1 | 0 | 0 | 0 | 0 | 0 |
| Endosome | 2 | 2 | – | 5 | 1 | 1 | 0 | – | 0 | 0 | 0 | 0 | – | – | – | 0 | 1 | 5 | 9 | 7 | 1 | 0 | 0 | 0 |
| Golgi | 0 | 1 | – | 0 | 0 | 0 | 0 | – | 0 | 0 | 0 | 0 | – | – | – | 1 | 1 | 3 | 0 | 2 | 0 | 0 | 0 | 0 |
| Mitochondria | 69 | 4 | – | 2 | 2 | 23 | 30 | – | 22 | 61 | 88 | 60 | – | – | – | 11 | 4 | 1 | 9 | 5 | 2 | 0 | 0 | 0 |
| Nucleus | 105 | 182 | – | 15 | 46 | 76 | 62 | – | 36 | 73 | 60 | 67 | – | – | – | 294 | 280 | 267 | 106 | 195 | 23 | 0 | 4 | 1 |
| Nuclear Periphery | 1 | 1 | – | 0 | 0 | 0 | 0 | – | 0 | 0 | 1 | 2 | – | – | – | 1 | 3 | 1 | 6 | 2 | 3 | 0 | 0 | 0 |
| Nucleolus | 3 | 0 | – | 1 | 0 | 0 | 1 | – | 0 | 0 | 0 | 1 | – | – | – | 1 | 1 | 1 | 5 | 6 | 0 | 0 | 0 | 0 |
| Peroxisomes | 0 | 0 | – | 0 | 0 | 0 | 0 | – | 0 | 0 | 0 | 0 | – | – | – | 0 | 1 | 0 | 0 | 0 | 0 | 0 | 0 | 0 |
| SpindlePole | 0 | 3 | – | 0 | 1 | 1 | 0 | – | 1 | 0 | 0 | 0 | – | – | – | 1 | 0 | 0 | 11 | 6 | 1 | 0 | 0 | 0 |
| Vac/Vac Membrane | 17 | 70 | – | 2 | 14 | 17 | 8 | – | 3 | 5 | 6 | 4 | – | – | – | 37 | 33 | 37 | 34 | 32 | 15 | 0 | 3 | 0 |
| Unique Cell Count | 176 | 248 | 24 | 74 | 116 | 102 | 49 | 108 | 126 | 104 | 353 | 332 | 319 | 209 | 275 | 54 | 1 | 12 | 6 | |||||
| Labelled Cell Count | 215 | 277 | 26 | 77 | 132 | 115 | 66 | 151 | 175 | 147 | 381 | 358 | 338 | 209 | 275 | 54 | 1 | 12 | 6 | |||||
Yeast GFP Assignment
Protein Abundance
| Screen | WT1 | WT2 | WT3 | RAP60 | RAP140 | RAP220 | RAP300 | RAP380 | RAP460 | RAP540 | RAP620 | RAP700 | HU80 | HU120 | HU160 | rpd3Δ_1 | rpd3Δ_2 | rpd3Δ_3 | AF100 | AF140 | AF180 |
|---|---|---|---|---|---|---|---|---|---|---|---|---|---|---|---|---|---|---|---|---|---|
| Mean Cell GFP Intensity (1e-4) | 4.1 | 5.6 | – | 5.9 | 6.1 | 4.9 | 5.1 | – | 3.7 | 3.9 | 3.7 | 3.6 | – | – | – | 8.5 | 8.5 | 8.6 | – | – | – |
| Std Deviation (1e-4) | 0.7 | 1.0 | – | 2.0 | 1.9 | 1.4 | 1.9 | – | 0.4 | 0.8 | 0.8 | 0.7 | – | – | – | 1.7 | 1.8 | 1.8 | – | – | – |
| Intensity Change (Log2) | – | – | – | – | – | – | – | – | – | – | – | – | – | – | – | – | – | – | – | – | – |
Localization Change
| Localization | RAP60 | RAP140 | RAP220 | RAP300 | RAP380 | RAP460 | RAP540 | RAP620 | RAP700 | HU80 | HU120 | HU160 | rpd3Δ_1 | rpd3Δ_2 | rpd3Δ_3 |
|---|---|---|---|---|---|---|---|---|---|---|---|---|---|---|---|
| Actin | – | – | – | – | – | – | – | – | – | – | – | – | – | – | – |
| Bud | – | – | – | – | – | – | – | – | – | – | – | – | – | – | – |
| Bud Neck | – | – | – | – | – | – | – | – | – | – | – | – | – | – | – |
| Bud Site | – | – | – | – | – | – | – | – | – | – | – | – | – | – | – |
| Cell Periphery | – | – | – | – | – | – | – | – | – | – | – | – | – | – | – |
| Cyto | – | – | – | – | – | – | – | – | – | – | – | – | – | – | – |
| Endoplasmic Reticulum | – | – | – | – | – | – | – | – | – | – | – | – | – | – | – |
| Endosome | – | – | – | – | – | – | – | – | – | – | – | – | – | – | – |
| Golgi | – | – | – | – | – | – | – | – | – | – | – | – | – | – | – |
| Mitochondria | – | – | – | – | – | – | – | – | – | – | – | – | – | – | – |
| Nuclear Periphery | – | – | – | – | – | – | – | – | – | – | – | – | – | – | – |
| Nuc | – | – | – | – | – | – | – | – | – | – | – | – | – | – | – |
| Nucleolus | – | – | – | – | – | – | – | – | – | – | – | – | – | – | – |
| Peroxisomes | – | – | – | – | – | – | – | – | – | – | – | – | – | – | – |
| SpindlePole | – | – | – | – | – | – | – | – | – | – | – | – | – | – | – |
| Vac | – | – | – | – | – | – | – | – | – | – | – | – | – | – | – |
| Cortical Patches | – | – | – | – | – | – | – | – | – | – | – | – | – | – | – |
| Cytoplasm | – | – | – | – | – | – | – | – | – | – | – | – | – | – | – |
| Nucleus | – | – | – | – | – | – | – | – | – | – | – | – | – | – | – |
| Vacuole | – | – | – | – | – | – | – | – | – | – | – | – | – | – | – |
External localization resources
Images






























Protein Concentration and Protein Localization Data
| R1 | R2 | R3 | ||||||||||||||||
|---|---|---|---|---|---|---|---|---|---|---|---|---|---|---|---|---|---|---|
| G1 Pre-START | G1 Post-START | S/G2 | Metaphase | Anaphase | Telophase | G1 Pre-START | G1 Post-START | S/G2 | Metaphase | Anaphase | Telophase | G1 Pre-START | G1 Post-START | S/G2 | Metaphase | Anaphase | Telophase | |
| Concentration | 0.6963 | 0.0097 | 0.1652 | -0.2379 | 0.2103 | 0.0248 | -0.2858 | -0.1569 | -0.2876 | -0.3093 | 0.0063 | -0.1873 | -0.1955 | -0.1519 | -0.5975 | -0.5789 | -0.802 | -0.2773 |
| Actin | 0.04 | 0.0004 | 0.0159 | 0.004 | 0.0121 | 0.0031 | 0.0186 | 0.0007 | 0.0234 | 0.0106 | 0.0311 | 0.0146 | 0.0229 | 0.0003 | 0.0051 | 0.0229 | 0.0003 | 0.0109 |
| Bud | 0.0006 | 0.0001 | 0.0002 | 0.0001 | 0.0022 | 0.0001 | 0.0003 | 0.0003 | 0.0006 | 0.0003 | 0.0002 | 0.0002 | 0.0099 | 0.0001 | 0.0035 | 0.0002 | 0 | 0.0029 |
| Bud Neck | 0.0061 | 0.0006 | 0.0012 | 0.0005 | 0.0046 | 0.002 | 0.0049 | 0.0007 | 0.0107 | 0.0004 | 0.0015 | 0.0032 | 0.0023 | 0.001 | 0.002 | 0.0011 | 0.0008 | 0.0043 |
| Bud Periphery | 0.0013 | 0.0001 | 0.0002 | 0.0002 | 0.0047 | 0.0002 | 0.0004 | 0.0008 | 0.0018 | 0.0008 | 0.0002 | 0.0005 | 0.0046 | 0.0001 | 0.0033 | 0.0002 | 0 | 0.0016 |
| Bud Site | 0.003 | 0.0004 | 0.0017 | 0.0005 | 0.0323 | 0.0002 | 0.0155 | 0.0068 | 0.0084 | 0.0005 | 0.0006 | 0.0003 | 0.003 | 0.0012 | 0.0033 | 0.0005 | 0.0002 | 0.0013 |
| Cell Periphery | 0.0003 | 0 | 0.0001 | 0.0001 | 0.0016 | 0.0001 | 0.0005 | 0.0004 | 0.0007 | 0.0001 | 0.0001 | 0.0001 | 0.0005 | 0.0001 | 0.0002 | 0 | 0 | 0.0002 |
| Cytoplasm | 0.0527 | 0.0742 | 0.041 | 0.0257 | 0.0457 | 0.0305 | 0.0457 | 0.0758 | 0.0616 | 0.0333 | 0.0203 | 0.0745 | 0.0628 | 0.1265 | 0.064 | 0.0677 | 0.1338 | 0.0455 |
| Cytoplasmic Foci | 0.0163 | 0.0034 | 0.0094 | 0.002 | 0.0076 | 0.0043 | 0.0252 | 0.0036 | 0.0076 | 0.0024 | 0.0217 | 0.0023 | 0.0226 | 0.0021 | 0.0089 | 0.0026 | 0.0035 | 0.0064 |
| Eisosomes | 0.0006 | 0.0001 | 0.0003 | 0.0001 | 0.0003 | 0.0001 | 0.0004 | 0 | 0.0002 | 0.0006 | 0.0002 | 0.0002 | 0.0003 | 0 | 0.0002 | 0.0003 | 0 | 0.0001 |
| Endoplasmic Reticulum | 0.0101 | 0.0041 | 0.004 | 0.0015 | 0.004 | 0.0016 | 0.0057 | 0.0066 | 0.0055 | 0.0013 | 0.0013 | 0.0072 | 0.0051 | 0.005 | 0.0036 | 0.0019 | 0.0018 | 0.0032 |
| Endosome | 0.0397 | 0.0041 | 0.0053 | 0.0045 | 0.023 | 0.0034 | 0.0086 | 0.0039 | 0.009 | 0.0081 | 0.0443 | 0.016 | 0.0316 | 0.0018 | 0.0072 | 0.0024 | 0.0024 | 0.0059 |
| Golgi | 0.0119 | 0.0001 | 0.0012 | 0.0015 | 0.0032 | 0.0015 | 0.0039 | 0.0005 | 0.0022 | 0.0039 | 0.0532 | 0.003 | 0.0102 | 0.0001 | 0.0024 | 0.0033 | 0 | 0.0031 |
| Lipid Particles | 0.0222 | 0.0006 | 0.004 | 0.0089 | 0.0053 | 0.0053 | 0.0114 | 0.0023 | 0.0105 | 0.0581 | 0.0203 | 0.002 | 0.0189 | 0.0002 | 0.0061 | 0.0071 | 0.0001 | 0.0042 |
| Mitochondria | 0.0139 | 0.0006 | 0.0015 | 0.0102 | 0.0585 | 0.0041 | 0.0026 | 0.0013 | 0.0021 | 0.0684 | 0.0078 | 0.0139 | 0.005 | 0.0005 | 0.002 | 0.0149 | 0.0004 | 0.0023 |
| None | 0.0711 | 0.1315 | 0.0781 | 0.0693 | 0.0165 | 0.0564 | 0.0902 | 0.1293 | 0.1246 | 0.0536 | 0.0783 | 0.1182 | 0.1017 | 0.1294 | 0.101 | 0.0454 | 0.1262 | 0.0185 |
| Nuclear Periphery | 0.0845 | 0.0745 | 0.1081 | 0.08 | 0.0338 | 0.0373 | 0.068 | 0.0448 | 0.0855 | 0.0158 | 0.0221 | 0.036 | 0.0662 | 0.0373 | 0.0502 | 0.0334 | 0.0658 | 0.0262 |
| Nucleolus | 0.0064 | 0.0053 | 0.0067 | 0.0063 | 0.0181 | 0.0108 | 0.0042 | 0.0082 | 0.0057 | 0.0027 | 0.0055 | 0.0099 | 0.0046 | 0.006 | 0.0047 | 0.0032 | 0.0064 | 0.0146 |
| Nucleus | 0.5589 | 0.6374 | 0.6557 | 0.7527 | 0.675 | 0.7748 | 0.6426 | 0.6746 | 0.5994 | 0.642 | 0.6385 | 0.6371 | 0.5801 | 0.626 | 0.6865 | 0.7043 | 0.6179 | 0.8039 |
| Peroxisomes | 0.0151 | 0.0001 | 0.0042 | 0.0056 | 0.0052 | 0.0019 | 0.0174 | 0.0017 | 0.0033 | 0.0037 | 0.0322 | 0.001 | 0.0143 | 0.0001 | 0.0026 | 0.0081 | 0 | 0.0025 |
| Punctate Nuclear | 0.0346 | 0.0599 | 0.0591 | 0.0245 | 0.0288 | 0.0606 | 0.0302 | 0.0338 | 0.033 | 0.0901 | 0.018 | 0.056 | 0.0269 | 0.0601 | 0.0407 | 0.0793 | 0.0388 | 0.039 |
| Vacuole | 0.0061 | 0.0018 | 0.001 | 0.0011 | 0.016 | 0.0012 | 0.0025 | 0.0033 | 0.0028 | 0.0012 | 0.0012 | 0.0025 | 0.0048 | 0.0019 | 0.0017 | 0.0007 | 0.001 | 0.0027 |
| Vacuole Periphery | 0.005 | 0.0007 | 0.0011 | 0.0008 | 0.0015 | 0.0006 | 0.0014 | 0.0008 | 0.0014 | 0.002 | 0.0011 | 0.0014 | 0.002 | 0.0005 | 0.0008 | 0.0004 | 0.0005 | 0.0007 |
Sequencing Data
| R1 | R2 | |||||||||
|---|---|---|---|---|---|---|---|---|---|---|
| G1 Post-START | S/G2 | Metaphase | Anaphase | Telophase | G1 Post-START | S/G2 | Metaphase | Anaphase | Telophase | |
| Gene Expression | 5.1846 | 1.6358 | 3.2369 | 8.987 | 5.1404 | 7.925 | 6.6157 | 9.4885 | 9.3232 | 8.8853 |
| Translational Efficiency | – | – | – | – | – | – | – | – | – | – |
Hit Data
| Dataset | Hit |
|---|---|
| Protein Concentration | ✘ |
| Protein Localization | ✘ |
| Gene Expression | ✘ |
| Translational Efficiency | – |
Endocytosis
| Temp | Actin Patch (Sac6-tdTomato) | Cortical Patch (Sla1-GFP) | Late Endosome (Snf7-GFP) | Vacuole (Vph1-GFP) |
|---|---|---|---|---|
| 37℃ | ||||
| RT |
Cell Cycle Omics
CYCLoPs (Yku70-GFP)
| Gene / Allele | Actin Patch (Sac6-tdTomato) | Cortical Patch (Sla1-GFP) | Late Endosome (Snf7-GFP) | Vacuole (Sac6-tdTomato) |
|---|
| Gene | Images |
|---|
| Gene | Images |
|---|
Images are not yet available
Images are not yet available